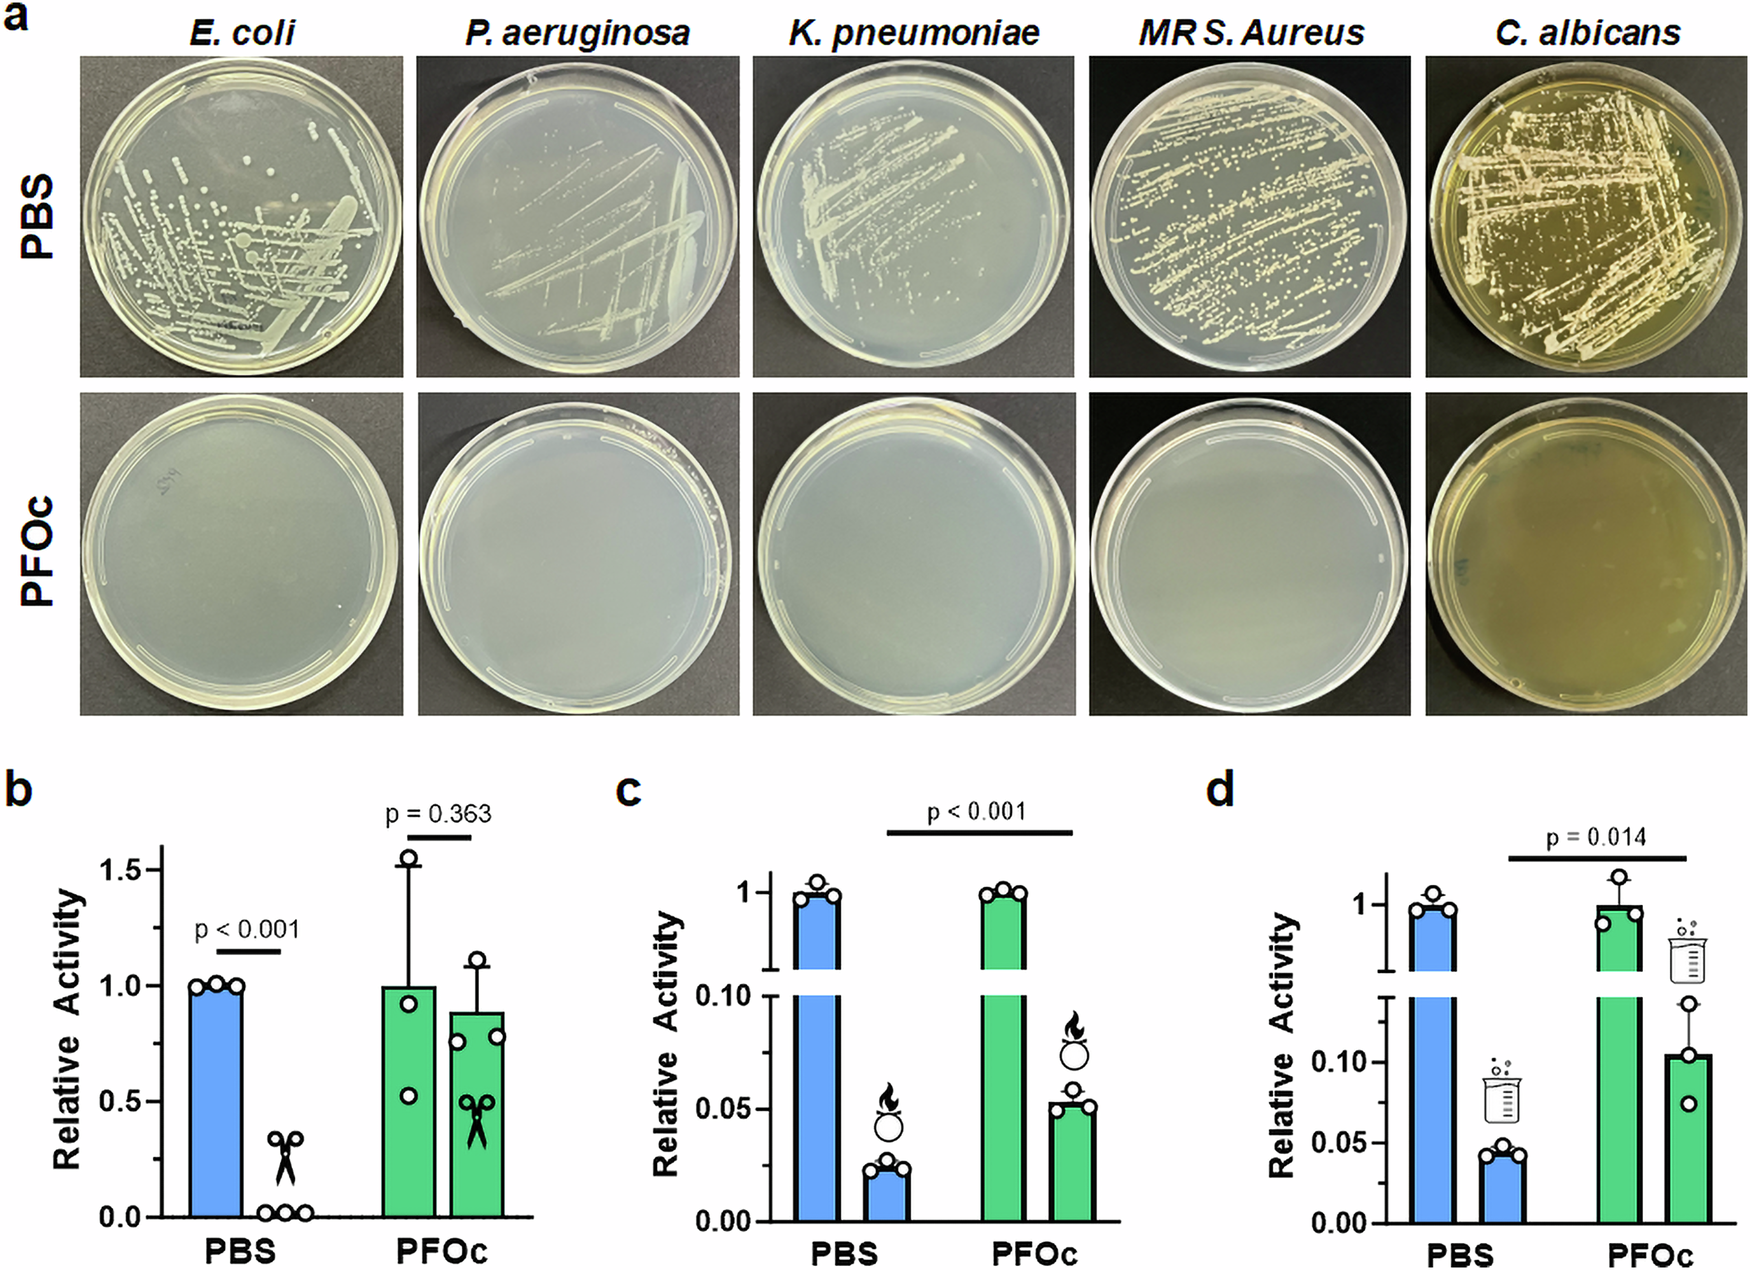
Fig. 4

Fig. 4: Shelf sterility and stability of fluorous protein formulations.
From: Heat stable and intrinsically sterile liquid protein formulations
a Representative optical images of agar plates after inoculation with PBS (top) or PFOc (bottom) BSA samples contaminated with the indicated pathogen. MR = methicillin-resistant. Relative activity of β-Gal protein dispersed in PBS (blue) or PFOc (green) solvents without (no icon) and with (icon) contamination by proteinase K (b), bleach (c), or hydrochloric acid (d). Data are shown as average ± s.d. of n = 3 technical replicates. Statistical significance between conditions is indicated by a line using one-sided Student’s t-test. Source data for panels b–d are provided as a Source Data file.
